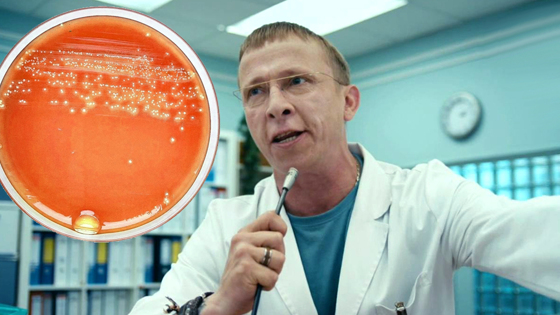

Пневмококковая инфекция, вызывающая отит и воспаление легких, ежегодно уносит жизни около 1,3 миллионов человек. Долгое время считалось, что заболеть пневмонией можно только при разговоре с болеющим, но недавнее исследование показало, что есть еще один вариант. Специалисты из Ливерпульского университета выявили, что инфекция способна переноситься на руках. Это значит, что если вы потрогаете нос грязными руками, например, после поездки в общественном транспорте, похода в магазин и даже после того, как вы держали в руках смартфон, вероятность занести инфекцию очень велика.
Ученые провели исследование: они распределили 40 взрослых на 4 группы. Первой группе просто нанесли на руки раствор, содержащий пневмококки. Второй предложили нанести сухую смесь с бактериями на руки и вдохнуть, держа руку на носу. Остальным было предложено тщательно потрогать нос влажными или сухими пальцами. В результате ученые выяснили, что независимо от влажности пальцев или действий с носом, шансы заразиться примерно равны. Но в сравнении, повышенные показатели наблюдались у тех, кто ковырял слизистую носа влажным пальцем. Единственный вариант - чаще мыть руки и пользоваться антисептиками.
Доктор Коннор сказал: «Возможно, нереально сделать так, чтобы дети перестали трогать, ковырять, протирать носы, но с другой стороны, бактерии в малом количестве могут выработать иммунитет. Пока нельзя сказать, что лучше для здоровья ребенка». Естественно, для родителей остается обязательным держать правило мытья рук после улицы.
Профессор, принимавший участие в эксперименте, говорит: «Мы все должны соблюдать строгую гигиену рук и основные правила по борьбе с инфекцией, такие как отказ от повсеместного питания, использование мобильных телефонов на улице и в транспорте, чтобы снизить риски. Вакцина - лучший метод защиты от болезни, но и та справляется не на 100%. Это уже задача департамента здравоохранения».